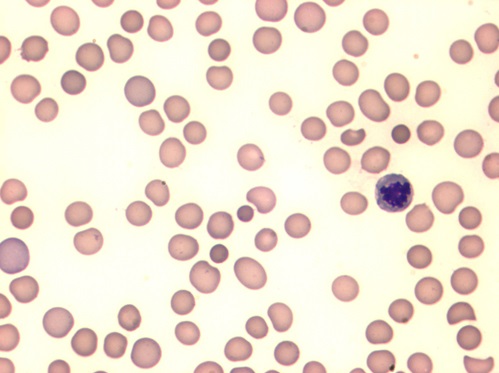
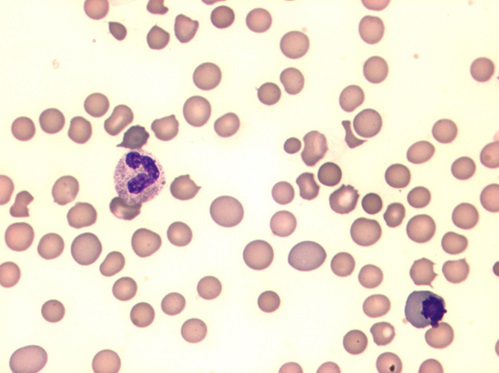

рмобласты 1
Нормобласты 1 109 фото
Курск к чему относится к какой
Шаман выступление 22 августа 2026
Какие у меня есть плюсы
Что сказал клаудиньо
Велосипед дорожный десна
Квартал публицист пушкино
Сбербанк открыт инвестиций
Стиральной машине мигает замок делать
Может быть через много лет
Образовательная программа дополнительному образования в школе